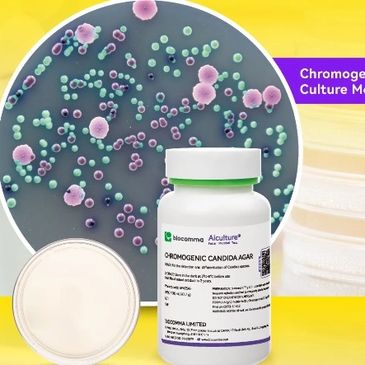

Iniciaste sesión como:
filler@godaddy.com
Iniciaste sesión como:
filler@godaddy.com

Nos especializamos en el desarrollo y producción de medios de cultivo microbiano y consumibles, ofreciendo soluciones integrales para análisis microbiológicos en las industrias alimentaria, cosmética y de control de calidad de agua, incluyendo medios deshidratados, granulados, cromogénicos, suplementos y consumibles de microbiología.
Los medios cromogénicos CommaChrom™ permiten la identificación de microorganismos mediante el desarrollo de colores específicos en las colonias, producto de la reacción entre enzimas propias del microorganismo y sustratos cromogénicos del medio. Esta tecnología ofrece mayor sensibilidad y especificidad en la detección y diferenciación de
Los medios cromogénicos CommaChrom™ permiten la identificación de microorganismos mediante el desarrollo de colores específicos en las colonias, producto de la reacción entre enzimas propias del microorganismo y sustratos cromogénicos del medio. Esta tecnología ofrece mayor sensibilidad y especificidad en la detección y diferenciación de cepas en comparación con los medios de cultivo tradicionales.

Aiculture® Pharmacopoeial Culture Medium es un medio de cultivo desarrollado que cumple con los estándares regulatorios vigentes. Está diseñado para aplicaciones clave como pruebas de esterilidad, límites microbianos y recuento microbiano, ofreciendo un soporte confiable y robusto para el control y aseguramiento de la calidad en la industria farmacéutica, laboratorios de ensayo y otros sectores.

Aiculture® se especializa en la investigación, desarrollo y producción de medios de cultivo microbiano y consumibles, ofreciendo soluciones continuas para la detección microbiológica en los sectores alimentario, farmacéutico, cosmético y de control de calidad de agua. Su catálogo de consumibles incluye bolsas de muestreo microbiano, bols
Aiculture® se especializa en la investigación, desarrollo y producción de medios de cultivo microbiano y consumibles, ofreciendo soluciones continuas para la detección microbiológica en los sectores alimentario, farmacéutico, cosmético y de control de calidad de agua. Su catálogo de consumibles incluye bolsas de muestreo microbiano, bolsas para homogeneizador, placas Petri plásticas desechables, asas de inoculación, esparcidores y kits de muestreo de superficies, entre otros.

Usamos cookies para analizar el tráfico del sitio web y optimizar tu experiencia en el sitio. Al aceptar nuestro uso de cookies, tus datos se agruparán con los datos de todos los demás usuarios.